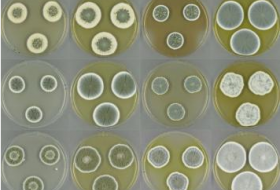

-
2017-05-11 15:22农业
广东海纳川生物拟登陆创业板据悉,广东海纳川生物是一家从事生产、销售兽药,货物进出口、技术进出口等的公司。招股书显示,公司拟发行不超过2970.80万股人民币普通股(A股)。 -
2017-05-11 15:17教育科研
江南大学生物工程学院召开“重温发酵历史”青年教师座谈会5月9日,江南大学生物工程学院“重温发酵历史”青年教师座谈会在生工楼茅台厅召开。全院40岁以下青年教师参加了座谈会,江南大学原校长陶文沂、生物工程学院院长许正宏出席座谈会。会议由生物工程学院党委副书记、副院长王珏主持。
-
2017-05-11 21:26农业
绿康生化总工程师郑求宪先生逝世郑求宪先生于2011年4月进入公司担任公司总工程师,并于2014年8月兼任公司质量法规总监。在公司任职期间,郑求宪先生忠诚始终,勤勉尽责,烙尽职守,献身事业,为公司的技术研发进步与可持续发展做出了卓越贡献。 -
2017-05-10 17:17医药
原料药出口有望回暖4月28日,中国化工报记者从世界制药原料中国展媒体交流会上获悉,2016年我国原料药出口保持量增价跌的总态势,出口量再创新高,出口价格继续下跌;2017年,原料药贸易有望回暖向好。 -
2017-05-10 17:04食品
安琪酵母的国际化之路今天,我们刊发《安琪酵母的国际化之路》一文,介绍安琪酵母,从一个30多人的科研机构起步,成长为中国酵母排头兵、国际知名酵母品牌的发展之路,以飨读者。
-
2017-05-10 17:00食品
安琪酵母“酵母中GSH纯化关键技术研究与产业化科研团队”再获30万元经费支持湖北省2016年度“双创战略团队”入选名单日前公布,安琪酵母股份有限公司“酵母中GSH纯化关键技术研究与产业化科研团队”继入围2015年全省30个C类科技创新战略团队后,此次由C类项目升为B类项目,再获30万元经费支持。 -
2017-05-10 16:56医药
共同药业“湖北省植物甾醇工程技术研究中心”获认定近日,省科技厅公式了《2017年度拟认定湖北省工程技术研究中心》名单,宜城市共同药业有限公司的“湖北省植物甾醇工程技术研究中心”榜上有名。至此,宜城市已有3家省级工程技术研究中心。 -
2017-05-10 16:07医药
致敬:这些一线的医药人大部分已年过七旬!说到医药行业的辛勤劳动者,可谓比比皆是。但这其中,有不少已经年过七旬仍坚持在工作一线的企业家们。今天的劳动者特辑,向这些不辞辛劳的医药人致敬!(排名不分先后)
-
2018-08-29 21:41农业
河南注销了27家饲料和饲料添加剂企业的生产许可证!近日, 河南公布了注销部分饲料和饲料添加剂生产许可证的名单。 -
2017-05-08 19:45食品
上海植生所在解脂耶氏酵母中迭代整合途径基因高产β-胡萝卜素β-胡萝卜素是一种四萜类化合物,常作为色素或营养添加剂用于食品和动物营养,目前主要由化学合成或三孢不拉霉发酵生产。β-胡萝卜素可由乙酰辅酶A(或丙酮酸和甘油醛-3-磷酸)经12步生物合成,将相关基因导入酿酒酵母或大肠杆菌可获得异源产β-胡萝卜素细胞。解脂耶氏酵母作为一种产油酵母,乙酰辅酶A供应充足,并能将高度疏水的萜类分子存储在胞内油滴中,具备高产β-胡萝卜素的潜力。
-
2017-05-08 19:37医药
深圳康体生命科技通过细菌和酵母表达羊驼单分子抗体 即将进入全国市场容益康表示,传统生物抗体行业面临诸多困难,比如从动物身上或细胞中提取抗体产量不高;多克隆抗体质量不稳定;单分子抗体制备过程复杂等;而康体生命能够用细菌酵母等微生物表达抗体,可以实现抗体的工业化大生产,极大降低生产成本获得高亲和力的单克隆抗体,实现抗体的精准靶向 -
2017-05-08 19:29综合
第十届中国生物产业大会将于7月3日在广州举办由广东省人民政府、中国生物工程学会等单位共同主办,广州市人民政府承办的第十届中国生物产业大会暨首届官洲国际生物论坛将于2017年7月3日至5日在广州白云国际会议中心举行。
-
2017-05-05 08:04教育科研
武汉病毒所人工合成杆状病毒杆状病毒是一类大的双链DNA病毒(基因组大小80-180 kb),在生物农药、真核表达系统等领域具有重要的应用价值。近期,中国科学院武汉病毒研究所研究员胡志红课题组联合运用PCR及酵母转化相关的同源重组(Transformation Associated Recombination, TAR)技术,首次合成了杆状病毒模式种AcMNPV的全基因组,并通过转染细胞成功拯救出了有感染性的人工合成病毒。
-
2017-05-04 16:22医药
东阳光药自研新药门冬胰岛素制剂及原料药获国家药监总局临床批件东阳光药(01558)发布公告,公司新药研发团队自主研发的治疗用生物制品门冬胰岛素原料药、注射剂及预混30剂型近日成功获得中国国家食品药品监督管理总局颁发的临床试验批件。 -
2017-05-04 09:03医药
武大校长窦贤康调研武汉生物技术研究院4月27日,校长窦贤康带队调研武汉生物技术研究院。武汉市委常委、东湖高新区党工委书记胡立山会见窦贤康一行。
-
2017-05-03 15:35食品
李晓燕:生物发酵产业现状及未来发展趋势4月21日,在广西柳州举行的第五届新型有机氮源应用与趋势发展研讨会上,中国生物发酵产业协会副理事长李晓燕出席会议,并作了题为:生物发酵产业现状及未来发展趋势的报告。
-
2017-05-03 15:30食品
庄英萍:基于氮源调控的生物过程优化与放大研究华东理工大学庄英萍教授在“基于氮源调控的生物过程优化与放大研究”的演讲中从多个维度阐述了如何实现高效的发酵调控与生产,着重讲述了氮源与过程代谢特性研究,并结合相关的应用案例展示了庄教授团队研究成果的应用效益。
-
2017-05-03 15:23食品
李江华:枯草芽孢杆菌代谢工程与氮源优化研究进展2017年4月21日,主题为“氮源科学调控,高效精准生产”的第五届新型有机氮源应用与发展研讨会在柳州顺利召开,江南大学李江华教授受邀作了题为“枯草芽孢杆菌代谢工程及氮源优化研究进展”的报告。报告主要展示了枯草芽孢杆菌代谢调控的最新研究成果,以及有机氮源优化的策略。
-
2017-05-03 15:18食品
谭文松:有机氮源在动物细胞大规模培养过程中的应用2017年4月21日“第五届新型有机氮源应用与发展研讨会”在广西柳城举行,华东理工大学谭文松教授做了题为“有机氮源在动物细胞大规模培养过程中的应用”的主题报告。
-
2017-05-03 15:12食品
于洪巍:代谢过程中关键酶的定向进化及高通量筛选方法的建立来自浙江大学的于洪巍教授作了主题为代谢过程中关键酶的定向进化及高通量筛选方法的建立的报告。于老师研究领域包括:酶固定化,酶定向进化及理性设计, 酶催化手性药物拆分及合成的研究;代谢工程。代谢工程与合成生物学技术手段的快速发展给异源化学品的生产带来了曙光。
-
2017-05-03 14:49食品
俞学锋董事长在第五届新型有机氮源研讨会开幕式上的致辞(节选)有机氮源是生物发酵产业链的重要环节,安琪酵母微生物营养一直致力于为中国生物发酵产业的创新升级提供高效、安全、稳定、清洁的新型有机氮源产品作为配套保障,安琪首创的酵母蛋白胨、填补国内空白的试剂级酵母浸出物、定向开发的多种专用型酵母浸出物等多种产品已得到众多生物发酵企业的认可,为配合生物发酵产业的高效清洁生产,提升产品附加值尽到了绵薄之力。
-
2017-05-03 09:16医药
利君生物制药基地项目再次成功列入“陕西省2017年重点建设项目”利君生物制药基地项目,继省十二届人大第四次会议审查批准,成功列入“陕西省2016年重点建设项目后,再次成功列入“陕西省2017年重点建设项目”。
-
2017-05-02 10:27食品
华中农大陈福生团队解开红曲色素生物合成路径谜团4月24日,我校食科院食品生物技术与安全研究团队在英国皇家化学学会的旗舰杂志Chemical Science杂志在线发表了题为“Orange, Red, Yellow: Biosynthesis of Azaphilone Pigments in Monascus Fungi”的研究论文。该项工作综合利用基因组学、分子生物学和代谢组学等技术,首次系统地阐述了红曲色素的生物合成途径。
-
2018-12-03 22:46食品
科学家在解脂耶氏酵母中迭代整合途径基因高产β-胡萝卜素中国科学院上海生命科学学习院植物生理生态学习所合成生物学重点实验室杨晟学习组与华东理工大学、浙江医药三方合作开发了解脂耶氏酵母基因组编辑工具(Gao S, Biotechnol. Lett.2014; J. Ind. Microbiol. Biotechnol .2016)。
-
2019-09-05 11:35医药
中国可造世界最新抗癌药 一年治疗费用不超10万近年来国内科研企业加大了抗癌药物的自主研发力度,一些具备国际最新科技水平的抗癌新药,已经进入临床试验阶段。
-
2017-04-27 22:46食品
石维忱理事长在第五届新型有机氮源研讨会开幕式讲话第五届研讨会的主题是“氮源科学调控高效精准生产”,主要探讨生物发酵产业如何从发酵工艺的氮源优化与调控入手,将后提取,环保、安全认证等诸多生产经营环节作为一个整体进行通盘考虑、寻求最佳解决方案,实现企业经营效益的最大化。
-
2017-04-27 15:45农业
第八届生物农药发展与应用交流大会5月17日在青岛召开由中国农药发展与应用协会主办的第八届生物农药发展与应用交流大会定于5月17日在山东青岛召开。会议将邀请国家主管部门相关领导及行业权威专家、学者、企业家共话生物农药发展。 -
2017-04-26 12:23制药
第三届中国放线菌生物学与产业化暨首届微生物药物学学术研讨会顺利召开2017年4月21-23日,由中国微生物学会分子微生物与生物工程专业委员会、重庆微生物学会主办,西南大学生命科学学院现代生物医药研究所为主承办的第三届中国放线菌生物学与产业化暨首届微生物药物学学术研讨会在西南大学桂园宾馆圆满落幕。
-
2017-04-26 09:50食品
新日恒力:出资2980万元购买微生物所月桂二酸菌种和发酵技术2017年4月26日公告,公司决定以自筹资金2,980万元购买中国科学院微生物研究所拥有的月桂二酸规模化生产中月桂二酸菌种、发酵、提取和精制等涉及的全套相关技术 -
2017-04-25 12:25医药
开发新型抗生素,将从真菌下手真菌或许能够成为抵御细菌和其他微生物引起的感染提供新的药物宝库。这是来自瑞典哥德堡查尔默斯技术大学的科学家们得出的结论。他们对数种真菌的基因组进行扫描并确认了 1,000 多种合成生物活性物质的路径。研究小组认为,这一研究结果可能是解决全球抗生素耐药性问题的重要一步。
发酵工业网手机版
打开微信右上角添加朋友中搜索公众号“发酵工业”,关注即可随时随地使用发酵工业服务。发酵工业微信更省心!






